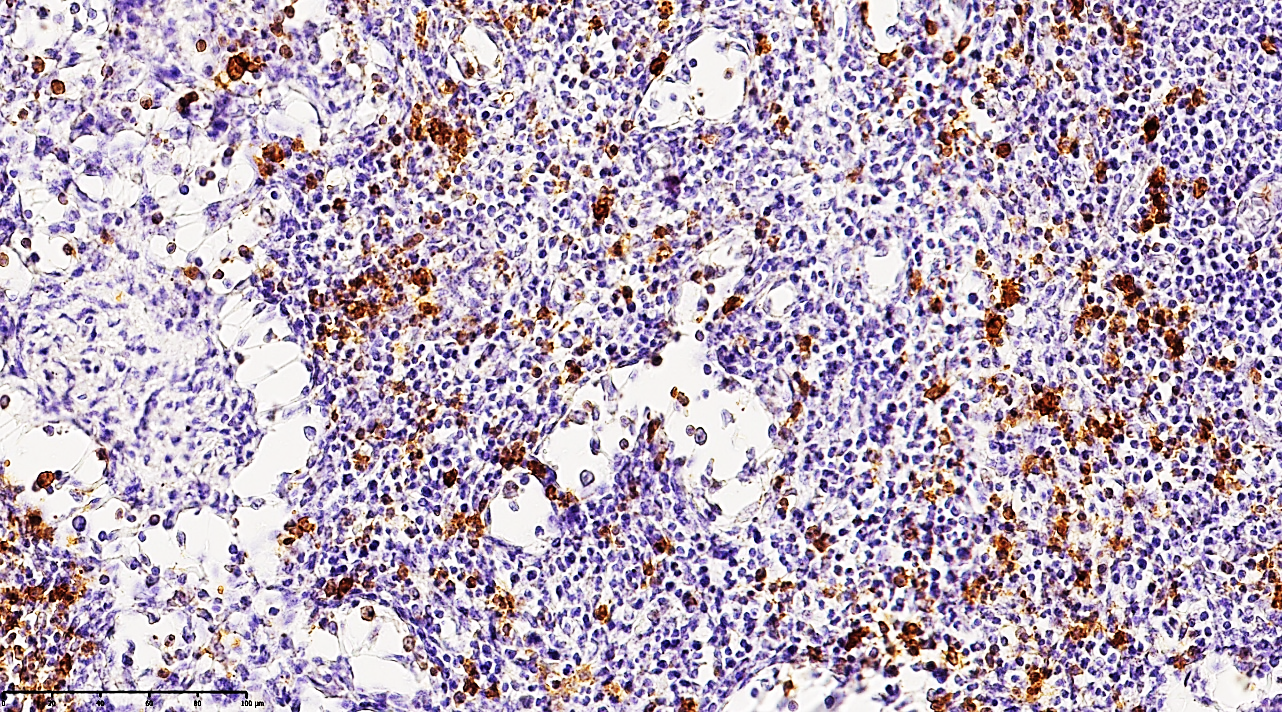

A. K. Khaydarov1, E. A. Eshbayev2
1Fergana Medical Institute of Public Health, Fergana, Uzbekistan
2Tashkent Medical Academy, Tashkent, Uzbekistan
Copyright © 2026 The Author(s). Published by Scientific & Academic Publishing.
This work is licensed under the Creative Commons Attribution International License (CC BY).
http://creativecommons.org/licenses/by/4.0/

Abstract
Acute secondary peritonitis is characterized by distinct immunohistochemical alterations in regional lymph nodes, primarily defined by lymphocytic depletion and compensatory reticulocytosis. This study analyzes the expression of CD3, CD4, CD21, CD45, and CD68 markers in mesenteric lymph nodes. Findings indicate a collapse of secondary germinal centers within lymphoid follicles, accompanied by a significant proliferation of CD68+ and CD45+ macrophages. A sharp decline in CD21+ surface lymphocytes was observed, alongside marked delimphatization (lymphocyte depletion) of the paracortical zones, specifically involving CD3+ and CD4+ T-cells. These immunohistochemical patterns confirm the development of a profound regional immunodeficiency state during acute peritonitis.
Keywords:
Lymph node, Peritonitis, Immunohistochemistry, Delimphatization, Lymphoid follicle, Immunodeficiency
Cite this paper: A. K. Khaydarov, E. A. Eshbayev, Immunohistochemical Characteristics of Regional Lymph Nodes in Acute Peritonitis, American Journal of Medicine and Medical Sciences, Vol. 16 No. 2, 2026, pp. 799-802. doi: 10.5923/j.ajmms.20261602.85.
1. Introduction
The high mortality rate of purulent peritonitis, which remains critically elevated worldwide between 20% and 60%, is largely driven by the rapid progression of endogenous intoxication culminating in Multiple Organ Dysfunction Syndrome (MODS) [1,2,3]. Global incidence rates reveal significant geographical disparities: while the USA and Europe report 10–15 cases per 100,000 population, and Turkey and Korea see 12–17 cases, the figures rise to 15–20 in Russia and the CIS, reaching a peak of 50–71 cases per 100,000 in Central Asia, Azerbaijan, and Armenia, where mortality rates can soar to 60–85% [4,5,6]. In Uzbekistan, this condition is particularly devastating in the pediatric population, contributing to the death of 700–1,300 infants under one year of age annually [7,8,9]. The regional lymph nodes serve as the primary "drainage system" for the abdominal cavity, yet their functional capacity is highly age-dependent; in infants aged 1–3 months, a physiological "paralysis" of this drainage system and sluggish circulation prevail [10,12]. By 3–6 months, reduced intestinal peristalsis combined with an insufficiency of the lymph node barrier function leads to local infection stasis and the development of lymphostasis, necessitating the development of precise, age-specific morphofunctional recommendations to improve clinical outcomes [11,13].
2. Materials and Methods
The study was conducted at the Republic Pathological Anatomy Center (2018–2023). The study cohort comprised 131 subjects, including a control group of 15 cases (mortality due to Ischemic Heart Disease and Myocardial Infarction). The aim: Tissue samples were processed for immunohistochemical (IHC) staining to evaluate the activity of CD3, CD4, CD20 (lymphocyte markers), and CD68 (macrophage receptors).
3. Results and Discussion
In the hyperacute phase of purulent peritonitis (days 1–3), a massive mobilization of lymphocytes toward inflammatory foci leads to a critical reduction of T and B cells within the regional lymph nodes.Key Findings:1. Follicular Collapse: Germinal centers in the marginal zones of cortical follicles showed significant atrophy and structural breakdown.2. T-Cell Deficit: Paracortical zones exhibited a sharp decline in CD3+ and CD4+ lymphocytes. Of the 33 patients studied in depth: 63.63% (n=21) showed a low positive reaction, while 36.36% showed a completely negative reaction.3. Reticulocytosis and Macrophage Infiltration: The paracortical areas showed increased reticular structures and an influx of large CD68+ macrophages. These cells were characterized by dark basophilic cytoplasmic inclusions.4. Proliferative Shift: While mature lymphocytes were depleted, the presence of small CD3+ and CD4+ positive cells (lymphoblasts) suggests a desperate attempt at proliferative activity despite the overarching state of immunodeficiency. | Figure 1. Mesenteric lymph node from a 21-year-old patient with acute secondary peritonitis. Immunohistochemical staining reveals a moderately low positive expression of the CD68 3 marker. Note the scattered distribution of macrophages and the depleted population of T-lymphocytes within the paracortical zones, visualized by the yellow-brown DAB (Diaminobenzidine) chromogen reaction. Counterstained with hematoxylin. Magnification: 10х10 |
 | Figure 2. Mesenteric lymph node of a 24-year-old patient with acute secondary peritonitis. The micrograph demonstrates a moderate-to-low positive immunohistochemical expression for the CD68 3 marker. In the paracortical regions, a sparse distribution of T-lymphocytes is observed, characterized by a distinct yellow-brown cytoplasmic staining. Staining: DAB chromogen. Magnification: 10х10 |
 | Figure 3. Mesenteric lymph node of a 27-year-old patient with acute secondary peritonitis. The image shows a moderate positive expression of the CD68 marker. Macrophages are predominantly identified within the cortical regions, exhibiting a distinct golden-yellow cytoplasmic staining. The underlying stroma demonstrates collapse of the medullary substance and the formation of interstitial edema. Staining: DAB chromogen. Magnification: 20х10 |
 | Figure 4. Mesenteric lymph node of a 24-year-old patient with acute secondary peritonitis. The specimen exhibits massive structural collapse of the nodal architecture. Immunohistochemical analysis shows low positive expression of the CD20 marker, indicating a significant depletion of the B-cell population. Distinct foci of reticulocytosis are observed throughout the parenchyma. Staining: DAB chromogen. Magnification: 20х10 |
The CD68 marker, primarily an adhesive membrane protein of macrophages, identifies these cells as they migrate from affected tissues through lymphatic vessels into the regional lymph nodes. In this study, out of 33 patients, 27 (81.81%) exhibited moderate positive expression, while 6 (18.18%) showed low positive reactions. These shifts confirm that a critical deficiency of immunocompetent cells within the lymph node triggers a compensatory increase in the phagocytic activity of macrophages. The observed enlargement of CD68-positive macrophages to giant proportions, characterized by dense, homogeneous, dark basophilic cytoplasmic inclusions, indicates an advanced state of phagocytosis following the ingestion of tissue debris. This phenomenon underscores that during the initial 1–3 days of acute peritonitis, a forced lymphatic drainage process occurs alongside the massive mobilization of lymphocytes toward inflammatory foci.Furthermore, a massive proliferation of CD68+ macrophages coupled with a profound depletion of lymphocytes is observed within the cortical and medullary layers, the paracortical zones, and the lymphoid follicles. This not only signifies the progression of secondary immunodeficiency but also reflects heightened proliferative activity of reticulocytes and an increase in fibroblasts and histiocytes. The chaotic formation of numerous reticular processes within the medullary cords, arising in response to the sharp decline in lymphocytes, indicates an intensifying process of massive delimphatization. Simultaneously, the accumulation of phagocytically active macrophages represents an attempt to fill the structural voids caused by nodal collapse, which is further exacerbated by the development of interstitial edema. The fraying and plasmatic swelling of the reticular fibers forming the medullary cords, combined with excessive fibroblast proliferation, allow for the prediction of burgeoning lymphoreticulosis and lymphoreticulosclerosis within the medullary substance.The drastic reduction of CD20+ B-lymphocytes, the delimphatization of lymphoid follicles in the cortical zone, and the predominant accumulation of macrophages within secondary follicles collectively indicate the development of focal lymphadenitis, a finding corroborated by neutrophil accumulation along the marginal surfaces of the follicles. In the paracortical zones, the residual small lymphocytes and lymphoblasts are found to have undergone incomplete apoptosis. Numerous reticulocytes and phagocytically active CD-receptor macrophages are identified surrounding these apoptotic and necrobiotic cells. Among the 33 cases studied, 11 patients showed a moderately low positive reaction for the CD20 marker, while 21 patients exhibited a completely negative reaction, further confirming the manifestation of severe secondary immunodeficiency as detailed above.
4. Conclusions
In summary, this study demonstrates that in acute secondary peritonitis, the mesenteric lymph nodes are the primary structures to undergo profound pathological transformation. This process is characterized by a significant loss of functional parenchyma and a critical depletion of CD3+, CD4+, and CD20+ lymphocytes. These cellular shifts are accompanied by a compensatory proliferation of CD68+ macrophages and a marked increase in reticulocyte density.Such alterations confirm the rapid mobilization of immunocompetent cells from the nodes to primary and secondary inflammatory foci, leading to the formation of localized zones of "delimphatization" and the progression of lymphoreticulosis. From a clinico-morphological perspective, these findings provide definitive evidence of acute immunological exhaustion and structural collapse within the mesenteric lymphatic system, underscoring the severity of the systemic immune failure in peritonitis.
References
| [1] | Aires J, Ilhan ZE, Nicolas L, et al. Occurrence of Neonatal Necrotizing Enterocolitis in Premature Neonates and Gut Microbiota: A Case-Control Prospective Multicenter Study. Microorganisms. 2023; 11(10): 2457. |
| [2] | Alsaied A, Islam N, Thalib L. Global incidence of necrotizing enterocolitis: a systematic review and meta-analysis. BMC Pediatr. 2020; 20: 344. |
| [3] | Andrade JAB, Freymüller E, Fagundes-Neto U. Pathophysiology of enteroaggregative Escherichia coli infection: an experimental model utilizing transmission electron microscopy. Arq Gastroenterol. 2010; 47: 306–12. |
| [4] | Aujla SJ, Chan YR, Zheng M, et al. IL-22 mediates mucosal host defense against Gram-negative bacterial pneumonia. Nat Med. 2008; 14: 275–281. |
| [5] | Aydemir G, Cekmez F, Tanju IA, et al. Increased fecal calprotectin in preterm infants with necrotizing enterocolitis. Clin Lab. 2012; 58(7-8): 841-4. |
| [6] | Berry MJ, Port LJ, Gately C, Stringer MD. Outcomes of infants born at 23 and 24 weeks' gestation with gut perforation. J Pediatr Surg. 2019; 54(10): 2092-2098. |
| [7] | Bethell GS, Knight M, Hall NJ. BAPS-CASS B-CNIGobo. Surgical necrotizing enterocolitis: association between surgical indication, timing, and outcomes. J Pediatr Surg. 2021; 56(10): 1785–90. |
| [8] | Bhatia AM, Stoll BJ, Cismowski MJ, Hamrick SE. Cytokine levels in the preterm infant with neonatal intestinal injury. Am J Perinatol. 2014; 31(6): 489–96. |
| [9] | Black RE, Cousens S, Johnson HL, et al. Global, regional, and national causes of child mortality in 2008: a systematic analysis. Lancet. 2010; 375: 1969–87. |
| [10] | Brusselaers N, Simin J, Lilja HE. Risk of neurodevelopmental impairment in Swedish preterm children treated for necrotizing enterocolitis: retrospective cohort study. BJS Open. 2024; 8(6): zrae131. |
| [11] | Burnand KM, Zaparackaite I, Lahiri RP, et al. The value of contrast studies in the evaluation of bowel strictures after necrotising enterocolitis. Pediatr Surg Int. 2016; 32(5): 465-70. |
| [12] | Gorbatyuk OM, Martynyuk TV, Shatrova KM. Clinico-morphological characteristics of gastrointestinal perforations in newborns. Russian Bulletin of Pediatric Surgery, Anesthesiology and Reanimatology. 2013; 3(2): 31-36. (In Russ.) |
| [13] | Gorbatyuk OM, Shatrova KM, Martynyuk TV. Morphological diagnosis of gastrointestinal perforations in newborns. Neonatology, Surgery and Perinatal Medicine. 2015; 5(3): 62-66. (In Russ.) |


 Abstract
Abstract Reference
Reference Full-Text PDF
Full-Text PDF Full-text HTML
Full-text HTML